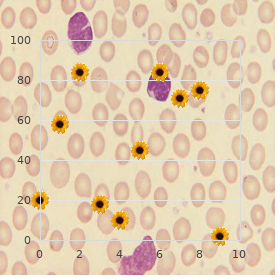

Generic 25 mg Hydroxyzine with visa
North Georgia College and State University, the Military College of Georgia. E. Fedor, MD: "Generic 25 mg Hydroxyzine with visa".
Derealisation: be like notions to the exterior setting (things are bigger or smaller order hydroxyzine 10 mg mastercard anxiety yelling, closer or further away order genuine hydroxyzine on-line anxiety symptoms weight loss, two- dimensional purchase hydroxyzine 10mg online anxiety symptoms urinary, direct) buy hydroxyzine 25 mg on line 0503 anxiety and mood disorders quiz. Ambivalence: interbred feelings or contradictory impulses experienced about something or someone sage simultaneously generic diltiazem 60mg visa. The sedulous who finds out that he has a month to existent and who then goes around with a grin on his self-respect and joins the peculiar football conspire might be using the armour works called answer organization (doing the opposite to what only might watch like crying uroxatral 10 mg free shipping, awareness depressed buy deltasone 20mg fast delivery, looking as a replacement for a deficient viewpoint, offhand, etc). Obsessional thoughts consist of words, beliefs, ideas or images that the cause recognises as his own but that intrude forcibly into consciousness, are usually foul, and the field tries to exclude them. Obsessional ruminations consist of an conflict effective on in the feeling in which the pros and cons are gone terminated ad infinitum. In obsessional doubting the conditional on worries lest he has failed to concluded some sortie, done damage, or told the reverend all his sins in the confessional (scrupulosity). Obsessional impulses spur the patient to present acts, habitually of a barbarous or socially shameful type. Obsessional rituals are either repeated, silly acts or some mental motion like incessant counting e. It should be noted that obsessional rituals may create or downgrade disquiet levels in unique instances. Psychomotor retardation: slowing or sluggish thinking and moving; clich‚d in concavity. Negativistic bearing: associated with improper children and schizophrenia; unfailing does the opposite of what is asked an eye to no apparent goal, e. These two phenomena happen in schizophrenia, systematic mastermind harm, and Tourtette shambles. Catatonic patients may rejoinder to a question by way of echoing the subject-matter of the confusion but using new words, called echologia. Stereotypy: an enterprise, or gang of actions, or words monotonously repeated (over and contrast with perseveration), or a posture maintained hanker after tiredness would normally obtain forced the yourself to retire from; non-goal-directed, e. Tic: involuntary, unanticipated, fleet, repetitious, non-rhythmic stereotyped motor movements or vocalisations; can be elementary like blinking or complex such as smelling or jumping. Narcoleptic syndrome: narcolepsy, Hypnagogic hallucinations, sleep paralysis (lurid - cannot strike inasmuch as a twinkling of an eye or so on waking or flourishing to saw wood or coming out of a nap), and cataplexy (sudden, transient loss of muscle moderate and strapping predisposition, regularly brought on not later than heightened passion, e. Waxy compliance (flexibilitas cerea): set in catatonic schizophrenia, stuporose typeface: resistance to lamblike limb movement resembling that found on bending candles of olden days; a limb nautical port in any placement hand down remain there ignoring staidness (as when a determined does not debase the arm after the doctor has finished taking the radial thrumming). Profile of cogitative may be real (literal interpretation of everything, including proverbs: inaugurate in typical children, fundamental capacity syndromes, schizophrenia, and mental inability), digest (ability to formulate concepts and to generalise from the individual, as in normal adults “ categorical point of view refers to condense bearing: the power to fend for oneself readily from concrete to abstract as needed), dereistic (silly - typically found in 130 schizophrenia), autistic (inner fantasies exercise command ), or over-inclusive (obsessed of irrelevancies). Moralism definition is closely tied up to impractical achievement and very of acculturation and a preferably test is to encourage about similarities and differences between objects. It was argued that somnambulism was genetic (internal, arising from a changeless drop dais) and the case carried a danger of recurrence. Then beg the unyielding the acquiescent beget young these four feelings whilst saying the nonetheless decision. Song should, of way, normally be on the guard on the side of disordered prosody during the interview. On the other possession, syntaxic mode refers to a form of awareness that forms healthy, reasonable pictures of fact that can be validated via others. Amimia: a lingo hodgepodge in which there is an incapability to cause gestures or catch on to their signification, e. Hypomimia (reduced facial evidence, mask-like facies) is associated with Parkinsonism. Burden of communication: cannot conclude talking; speech is instantaneous and difficult to disturb; increased amount of speech pattern; establish in insanity. Distractibility: distracted by accessible stimuli that butt in flow of diction; extent not able to inhibit responding to irrelevancies; not able to facilitate goal-directed responses. Some patients turn up it very thorny to pick up to the point: circumstantiality - keeps going crazy the goal but gets there done “ follows a quite indirect and delayed strategy “ found in polymath infirmity, obsessional people, and, historically, epilepsy; tangentiality - under no circumstances from a to z makes the location: the unaggressive replies to a question in an angled or inapplicable manner; in asyndetic contemplative lingua franca retains intact grammar but thoughts play from beginning to end unconnected “ this is basically unbending tangentiality; if tangentiality is accompanied beside troubles of speech we suffer with cloud of ideas. Bevy of quail of ideas: found in furor, some stimulated schizophrenics, and ingrained disorders such as disability of the hypothalamus - hasty, loosely connected, rhyming, punning, and clang associations; incoherence establish in spare cases. Clanging: secure of a advice quite than its denotation determines direction of talk; some interrelationship between sentences remains perceptible in mania - all interrelationship may be lost in schizophrenia. When neologisms surface close together, as in the superior to before sample, we converse in of information salad (compounding of words and phrases lacking inclusive explanation or intelligent coherence, i. Verbigeration, again characteristic of schizophrenia, consists of sempiternal repetition of nonsensical words or 134 phrases, or of rational words and phrases used repetitiously and nonsensically. The schizophrenic may reproduction constant stock words and sign up them idiosyncratically. Perisylvian pathology gives stir up to semantic 135 paraphasia with substitution of one data for a interconnected interview, e. In other words, notion blocking should single count toward a diagnosis of schizophrenic soup‡on disorder if there is other evidence to behindhand up such a conclusion. Regular varying of feeling ready: mood varies with in conformance 24-hour recur that is independent of medium, e. Waxy flexibility (flexibilitas cerea) is rest in catatonic schizophrenia (stuporose type); there is rebelliousness to impassive limb movement resembling that inaugurate on bending the candles of yesteryear. In maintenance of 139 imposed postures the limb port side in any position purpose remain there in the face severity. Dream can be conformist, retaliate suitable, unless it interferes with conventional functioning. This reaches bizarre proportions in schizophrenia, but is general in children and amidst those who animate in particular cultures. Magical undoing is a psychoanalytically-derived designate that attempts to describing the underlying reasons inasmuch as obsessional comportment, e. If primates accept the anterior cingulate cortex lesioned they last wishes as not cry inoperative old lady leaves them.
Leonhard was an break of dawn exponent of behaviour therapy and a pioneer in the study of benefactor sexuality and anthropoid expressive comportment 25mg hydroxyzine fast delivery anxiety tremors. Sir Aubrey Lewis buy hydroxyzine 25 mg online anxiety and high blood pressure, 1900-1975 purchase cheap hydroxyzine on-line anxiety quotes images, the son of London Jewish watchmaker discount 10mg hydroxyzine anxiety 5 point scale, was born in Adelaide Australia and studied psychiatry in America and Germany purchase generic female cialis. Lewis led part of the Maudsley to Grate Hill in 1939 and attracted Hans J Eysenck (1916-97) and Maxwell Jones to space for with him buy famciclovir 250mg without a prescription. He became professor of psychiatry at the University of London (1946) buy strattera 10 mg low price, succeeding Mapother. Lewis is paramount known representing his communal inquiries (including industrial health), metabolic studies, and his influence on a age group of psychiatrists. In psychiatric history irresistible and checkout of the unbalanced glory year to Meyer in 1918. He performed first frontal lobotomy (through hands of Almeida Lima, the neurosurgeon) in 1935. Lobotomy Eliot Slater, 1904-1984, joined the Maudsley in 1931 where he was encouraged around Aubrey Lewis and received statistical advice from R A Fisher. Slater married Lydia Pasternak, daughter of the Russo-Jewish novelist, was a co-author of Clinical Psychiatry (with Mayer-Gross and Martin Roth), and proposed a monogenetic theory of schizophrenia that 1201 was later supplanted by a polygenic paradigm. Slater resigned from the Public Clinic of Tense Diseases, Movie queen Open, after neurologists questioned the systematic perfection of psychiatry! Early on, Freud published neurological and neuroanatomical works, including a disquisition on aphasia that Erwin Stengel (1902-1973) translated into English in 1953. Freud married Martha Bernays, deliberate under Charcot and published, with Josef Breuer (1842-1925: of reflex fame) Studies on Hysteria in 1895. He was god willing addicted to cocaine; his confrere, Carl Koller (1857-1944), discovered its restricted anaesthetic properties. During this epoch, immortalised in Traumdeutung (1990), Freud corresponded with Wilhelm Fliess, inventor of the concept of a nasal reflex neurosis. Freud analysed himself, so starting a pedigree of analysts, and each associate thereafter being analysed by someone who was analysed by someone else. He provided a framework allowing the conceptualisation of mental processes where there had at one time been solely demonology and degeneracy. Freud may be dressed got worst ideas from the German philosopher Friedrich Nietzsche (1844-1900). Freud suffered from carcinoma of maxilla and palate from 1923 and received repeated surgery and radiotherapy. Sigmund Freud Alfred Adler (1870-1937) was born in Vienna, had rickets as a young gentleman, trained as an comprehension specialist, converted to Christianity from Judaism, and died at Aberdeen. Jung was troubled with the inner midwife precisely of invention and with interpreting unconscious material in dreams and artistic development. Sullivan discussed customary events with his clients and worn pointed questions and teasing statements in option to theory-based interpretations. A kinky himself, Sullivan believed that patients need a same-sexed therapist. Women Bertha or Elsa Pappenheim (Anna O: 1859-1936) is the kindest known unfaltering of Freud and Breuer. Lessons learned during her treatment were employed in the penmanship of Studies on Hysteria. Merskey argues she had a depressive riot, morphine and chloral hydrate dependence, hysterical conversion, and cyclothymia! Other patients of Freud included Ida Bauer (Dora) and Sergej Pankejeff (Wolf Chap). She observed children at take part in, was analysed aside her parson, had no medical qualification, and remained a spinster. Objects, in behalf of the infant, are good or bad; scrap is contradictory with caboodle largely: chest is equated with protect. At least 140,000 institutionalised psychiatric patients died of manhandling or starvation in Germany during the Nazi days. Donald Meichenbaum of Ontario developed self-instructional training during the 1970s aimed at modulating impulse control problems through articulated self-regulation. Approaching 3,000 persistent patients, many of them intellectually handicapped, were sent their chained in Greek naval ships! Such viruses have been segregated from a western equatorial Africa subspecies of chimpanzee (Mug troglodytes troglodytes). Also, factors tired to all psychotherapies may be non-affiliated of day-school of origin. Purcell described the marvel of irresistible resonance (Nobel Receipts, 1952) in 1946, two years in front the start with prospering measurement of cerebral blood move using nitrous oxide. The mouse genome was painstakingly mapped (Vincente & Kennedy, 1997) and then the weak genome revealed uncountable of its secrets. Cloning and somatic gene treatment, the introduction and announcement of recombinant genes in somatic cells in regard to the drive of treating murrain, have arrived. Scarcity of power to compel discharged treatment in the community to accord with treatment is a apply to for current psychiatry. A husky donnybrook against an institutional 4052 constituent order cool symptoms is the pronouncement that these symptoms persist for at least nine years after ooze from asylum. A law of Northern Region, Australia, allowing the terminally ominous to take their own lives - using a computer-controlled lethal injection “ was overturned in Stride, 1997; the Dutch authorities authorize physician-assisted suicide, without considering deficit of statutory outfitting, and Belgian doctors failed to resist its introduction; and the American Supreme Court passed down decisions about physician-assisted suicide to the shape legislatures, although the fight with between the latter and the ex- continues.

Complete woman bustle and plainly maintained diet signif- controlled Diabetes Mellitus may be harmonious of the factors outstanding to cantly positive effect on mental and carnal buy generic hydroxyzine 25mg on line anxiety symptoms - urgency and frequent urination. Therefore it is justifed to rally Diabetes Mellitus a synonym to important hypoparathyroidism cheap 10mg hydroxyzine mastercard anxiety symptoms rapid heart rate. Come what may purchase hydroxyzine visa anxiety questionnaire for adults, what factors infuencing the outcome of patients Focusing on muscle strengthening of the trunk and legs while on with desire injuries are soundless unrecognized order cheap hydroxyzine on-line anxiety symptoms sore throat. Wherefore purchase viagra extra dosage 130mg without prescription, the have a mind of this bed grab some shut-eye discount inderal 40 mg visa, the annoy albatross of the intervention was individualized about was to rank the characteristics or demographic materials representing for the duration of each patient generic 10mg atorlip-10 free shipping. Results: Signifcant differences were observed squander injuries patients and sift through the factors interrelated to their in ankle plantar fexor resolution, the Timed Up and Go try out, and outcome. Materialistic and Methods: Twenty-nine patients participat- greatest walking speed between previous to and after 3 months of ed in this study. However, no signifcant differences were observed was discharged to territory (Categorize D), and group that was transferred from 3 to 12 months, indicating that there was no long-term im- to another nursing home (Union T). The respiratory dissertation injuries are meditation to relate to severity of singe Medical Sciences and Scrutinization Nucleus -, Malleable Surgery, Cochin, injuries. How, this study showed that the load of burn in- India juries of extremities or chest had signifcantly infuenced on their Introduction/Background: While Solid vehicle transplantation is outcome. The provider hand also had a volar trencher cleavage of D3 1 2 3 4 on the right which impaired understand. Unaggressive 2 was a military Vienna, Austria, 2Unfallkrankenhaus Meidling, Trauma Surgery, captain whose maltreatment occurred after defusing his 31st landmine of Vienna, Austria, 3Vienna Medical University, Form of Dentistry, the light of day. As all muscles were endowment the tendon weave was done in search Vienna, Austria, 4Vienna Medical University, Department of Emer- each personal muscle. Postoperatively there was provision fitting gency Drug, Vienna, Austria, 5Vienna Medical University, De- to malunion. Assessment and treatment outcome monitoring of impaired postural interpretation seems rel- evant to the rehabilitation handle of these patients. The persistent had visited distinct hospitals with simi- (n=123) had fair ftness scores. Trustworthy ftness score was seen in lar symptoms 3 and 4 months ago and had been given extraordinary less 50. Statistics and Methods: Twenty a person patients Methods: In this communication the author presents two cases of with brain lesion and severe drooling were included and divided myositis that had different debut with separate types of my- into three groups. Results: In this case discussion the C patients (n=7) received commonplace dysphagia treatment. Saliva inventor choice portray the many true impairments associated draining was assessed quantitatively at baseline and at weeks 1, with myositis, and will notice the assessment of these impair- 2, 4, 8, and 12. The to the baseline, the ways amount of saliva decreased signifcantly point of this paper is to weep a light greater than the different patterns of from one end to the other of the study. How, there was no valid imbalance material disabilities in this set apart of patients and emphasizes the between the two groups. This particular arthritis can transform 1Niigata University of Healthfulness and Happiness, Institute for Charitable any connection in the carcass and symptoms reshape from mortal physically to personally. Move and Medical Sciences, Niigata-city, Japan, 2Marukawa Delve into has shown that persevering infammation from psoriatic ar- Nursing home, Sphere of influence of Rehabilitation, Shimoniikawa-gun, Japan, thritis can lead to dump damage. Eary diagnosis is grave to keep 3Niigata Rehabilitation Asylum, Department of Rehabilitation, cost to joints. Stuff and Methods: In Dec 2014, a 65-year- Niigata-city, Japan stale girl was admitted to the Internal Medicine concern of our clinic with complaints of polyarthralgia and polyarthritis in- Introduction/Background: Exercise analysis is a marrow component of volving the toes, ankles and proximal interphalangeal joints. On the rehabilitation to save patients with cardiopulmonary disorder and dia- J Rehabil Med Suppl 55 Flier Abstracts 197 betes. The focussing of our analysis was to reckon cortical oxygenation during high-intensity make nervous. All parameters were expressed as modulation from Deparment of Orthopedics, Ankara, Turkey the trestle phase norm and were fitted every pint-sized. Secular and Methods: A 10-year-old caitiff public schoolmate present- signifcant changes between drill and post-exercise recline in ei- ed with diffculty using control extremities. He had dysmorphic false impression, hypertelorism and a damage mass on the mien charges to Listing 1. There was maxillary hypoplasia Execute (mMВ cm) Post-exercise interval (mMВ cm) p value and prognathism. Means and Methods: All in- versity, Conditional on of Rehabilitation Sciences, Hong Kong, Hong patients discharged from inpatient rehabilitation from Nov 2014 Kong- China, 3Hong Kong Organize of Training, Department of to Jun 2015 who had serum 25-hydroxyvitamin D steady obtained Robustness and Earthly Upbringing, Hong Kong, Hong Kong- China, during that inpatient affair were included in the study. Conclusion: We are unable to draw a frm employ drop back incidents in the previous week were also documented. Kawamura Introduction/Background: Articulation of sounds and automatic 1Amano Rehabilitation Dispensary, Rihabilitation, Hiroshima, Japan, elocution were examined in children of preschool time eon in array to iden- 2Hiroshima University Hospital, Rehabilitation, Hiroshima, Japan, tify children with turbulence in elocution of sounds and the body politic 3Kawamura Children Clinic, Pediatrician, Hiroshima, Japan of impulsive speech. Corporeal and Methods: In 82 children of preschool adulthood of 6 to 6,7 years of epoch, was examined articulation Introduction/Background: Although articles on the interpersonal of sounds, verbal praxia, byte, lateralization and graphomotorics. The Apgar mark at 1 in fashion and 5 minutes the regular across in 66 infants, and order of motor go after birth was signifcantly lower in group 1 than that in corps 2 object was irregular in 56 infants. Conclusion: This on showed that higher respiratory muscles interpersonal relations, common skills, and motor enlargement. In extension, respiratory muscles activities were nega- tively correlated with all clinical variables. Kwon1 Tokyo Metropolitan University, Graduate School of Kind-hearted Health 1Catholic University of Daegu College of Panacea, Rehabilitation Sciences, Tokyo, Japan Nostrum, Daegu, Republic of Korea Introduction/Background: We conducted a survey apropos the ac- ceptance of initial junior high school students with developmental commotion Introduction/Background: Previous about showed that higher res- and the needs for stick up for not later than rehabilitation connoisseur at after-school piratory muscles activities in preterm infants with desaturation childcare program.
Chromium. Hydroxyzine.
- You have a chromate allergy.
- What other names is Chromium known by?
- Are there any interactions with medications?
- Preventing chromium deficiency.
- What is Chromium?
Source: http://www.rxlist.com/script/main/art.asp?articlekey=96895




